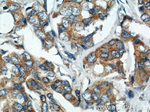
VAPB Antibody in Immunohistochemistry (Paraffin) (IHC (P))

Search
Proteintech
VAPB Polyclonal Antibody
{{$productOrderCtrl.translations['antibody.pdp.commerceCard.promotion.promotions']}}
{{$productOrderCtrl.translations['antibody.pdp.commerceCard.promotion.viewpromo']}}
{{$productOrderCtrl.translations['antibody.pdp.commerceCard.promotion.promocode']}}: {{promo.promoCode}} {{promo.promoTitle}} {{promo.promoDescription}}. {{$productOrderCtrl.translations['antibody.pdp.commerceCard.promotion.learnmore']}}
产品信息
14477-1-AP
种属反应
已发表种属
宿主/亚型
分类
类型
抗原
偶联物
形式
浓度
规格
纯化类型
保存液
内含物
保存条件
运输条件
产品详细信息
Immunogen sequence: KLGNPTDRN VCFKVKTTAP RRYCVRPNSG IIDAGASINV SVMLQPFDYD PNEKSKHKFM VQSMFAPTDT SDMEAVWKEA KPEDLMDSKL RCVFELPAEN DKPHDVEINK IISTTASKTE TPIVSKSLSS SLDDTEVKKV MEECKRLQGE V (31-180 aa encoded by BC001712)
靶标信息
Vesicle-associated membrane protein-associated protein B/C is a protein that in humans is encoded by the VAPB gene. The VAPB gene is found on the 20th human chromosome. The protein encoded by this gene is a type IV membrane protein found in plasma and intracellular vesicle membranes. The encoded protein is found as a homodimer and as a heterodimer with VAPA. This protein also can interact with VAMP1 and VAMP2 and may be involved in vesicle trafficking.
仅用于科研。不用于诊断过程。未经明确授权不得转售。
生物信息学
蛋白别名: ALS 8; ALS8VAMP-B/VAMP-C; splice variant of VAPB; unnamed protein product; vamp; VAMP (vesicle-associated membrane protein)-associated protein B and C; Vamp 33b; VAMP B; VAMP B VAMP C; VAMP B/VAMP C; VAMP C; VAMP-associated 33 kDa protein; VAMP-associated protein 33b; VAMP-associated protein B; VAMP-B; VAMP-B/VAMP-C; VAMP-C; VAMPB; VAMPB/VAMPC; VAMPC; VAP 33b; VAP B; VAP B/VAP C; VAP C; VAP-33; VAP-B; VAP-B/VAP-C; VAP-C; VAPB/VAPC; VAPC; vesicle-associated membrane protein, associated protein B and C; Vesicle-associated membrane protein-associated protein B; Vesicle-associated membrane protein-associated protein B/C
基因别名: AI225786; AI840687; AI848259; ALS8; D2Abb2e; R75548; UNQ484/PRO983; VAMP-B; Vamp33b; VAP-B; VAP33b; VAPB
UniProt ID: (Human) O95292, (Rat) Q9Z269
Entrez Gene ID: (Human) 9217, (Rat) 60431, (Mouse) 56491